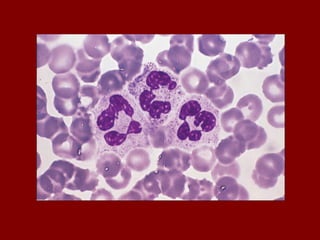
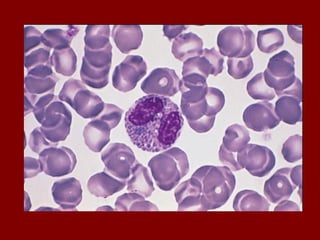
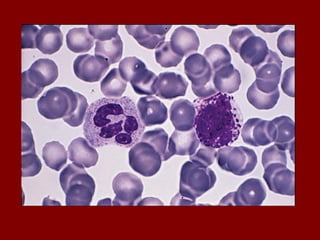
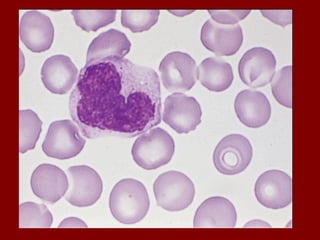
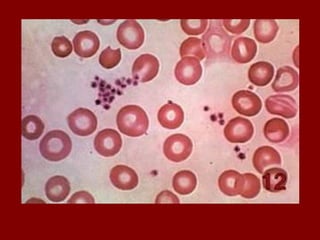
Sangue pdf

O documento descreve as principais células do sangue, incluindo eritrócitos, leucócitos, plaquetas e suas funções. Detalha os tipos de leucócitos como granulócitos e agranulócitos, e discute anemias, doenças relacionadas a cada tipo celular, e suas características morfológicas e funções no corpo.